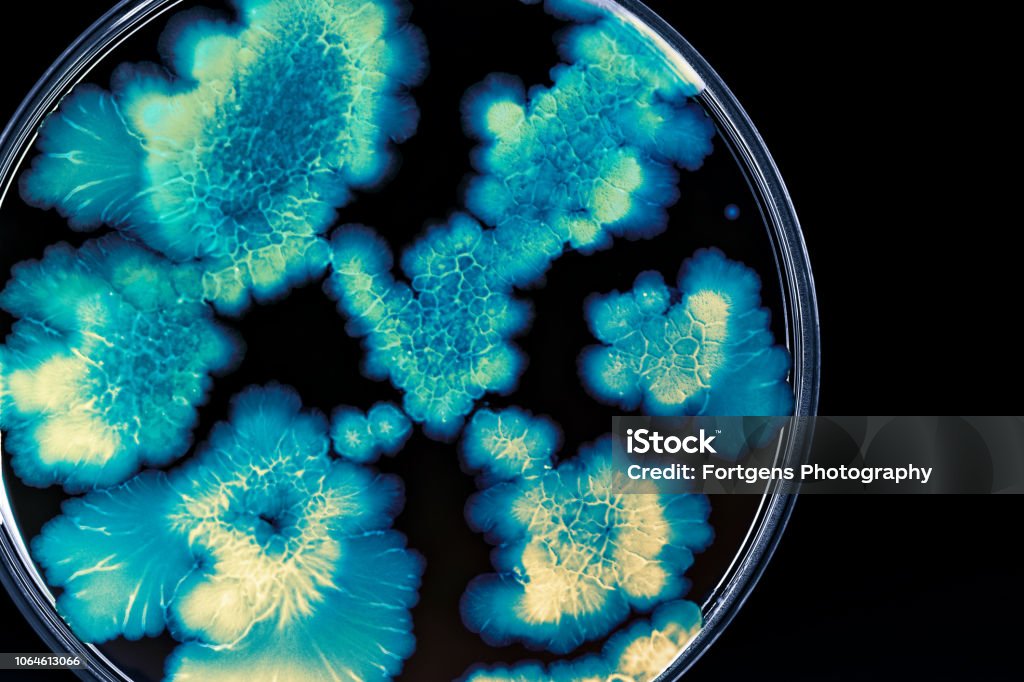
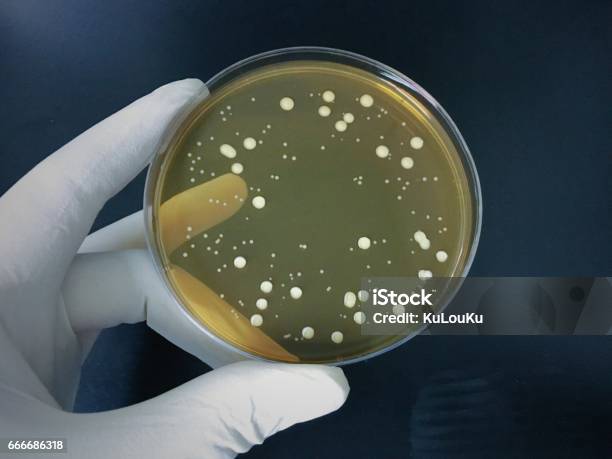

Научные эксперименты: ботулизм в чашке Петри

Раздел: Сокровищница опыта